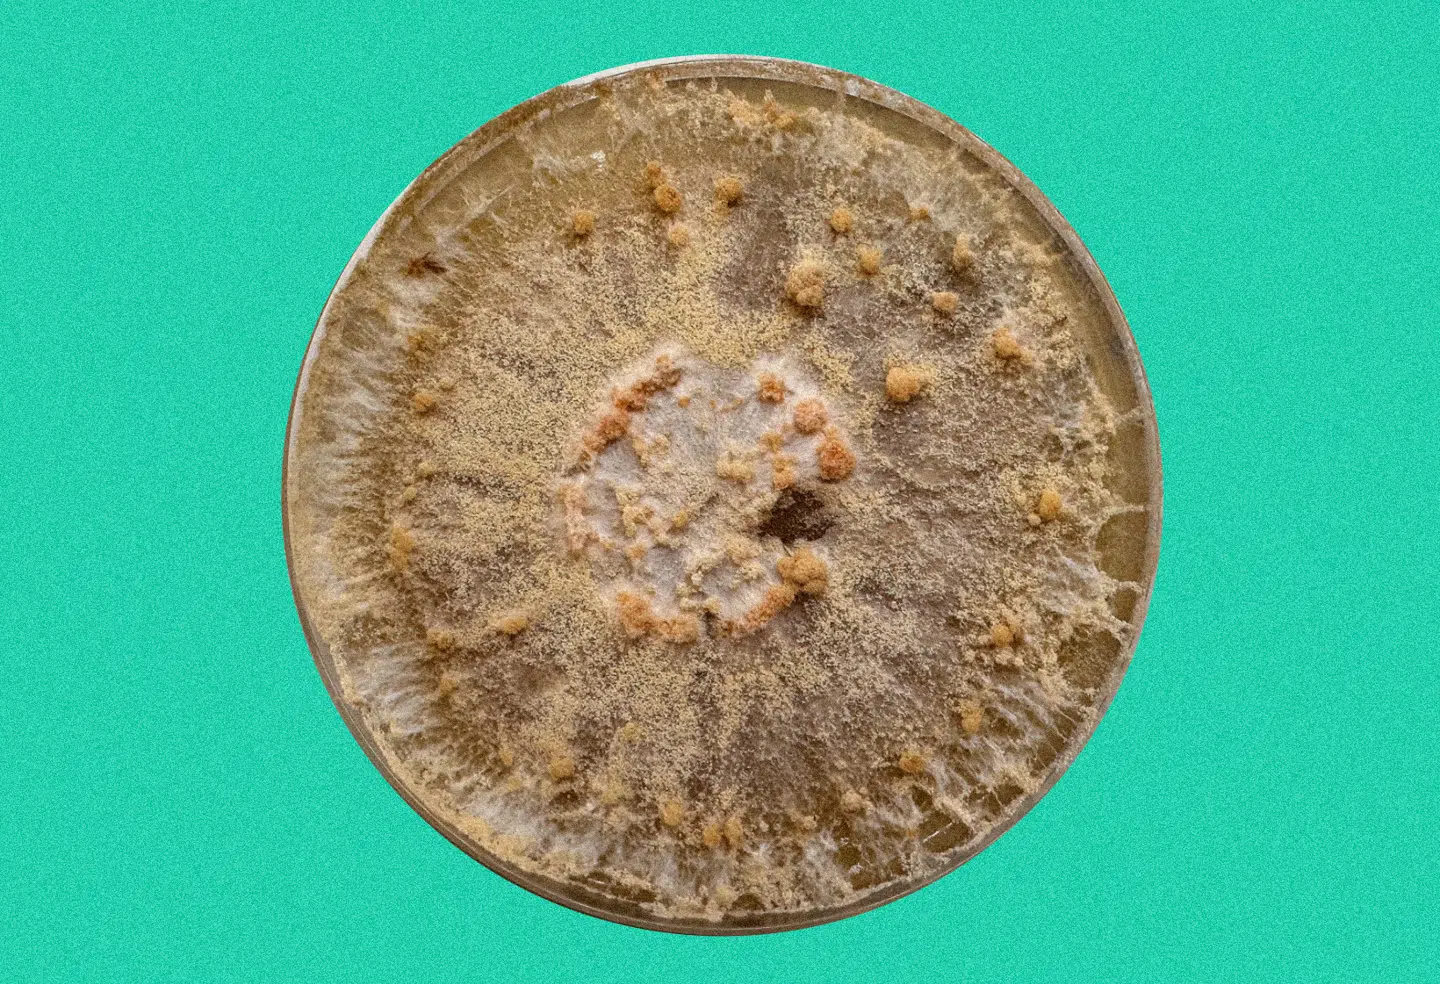

Falsificeret. Selv når forskere tror, de er allermest diskrete, opdager narhvalen dem.
Overvågning opdaget
I Falsificeret udfordrer vi hver uge vedtagne sandheder, afliver forældet viden og ser på fusk og fejl i forskningens verden.
Det, vi troede, vi vidste
I mange år har marineforskere studeret havets dyr på en særlig diskret måde ved at lægge lydoptagere ud tæt på havbunden og lade dem lytte i stilhed. Metoden er kendt som passiv akustisk overvågning og har blandt andet været brugt i studiet af narhvalen, der er en særligt sårbar arktisk tandhval. Den lever i isfyldte fjorde, har lange dykningsperioder og er følsom over for menneskelig forstyrrelse. Den er dermed en art, hvor skånsomme metoder er særligt vigtige, og den passive overvågning har derfor været anset som noget nær perfekt i forskningen.

Det, vi ved nu
En ny undersøgelse fra Inglefield Bredning i Nordvestgrønland viser imidlertid, at narhvalerne ikke betragter disse måleinstrumenter som usynlige gæster. Tværtimod søger de hen til dem og støder ind i dem igen og igen. På lydoptagelserne kan man høre hvalernes kliklyde blive hurtigere, lige inden de rammer, som om de målrettet undersøger genstanden.
Der er derfor ikke tale om tilfældige sammenstød, men det er uklart, hvorfor hvalerne gør det. Det kan være nysgerrighed, hvor et mystisk objekt tæt ved havbunden skal undersøges, men det kan også være, at narhvalen jager fisk, som giver et bestemt ekko, og måske lyder instrumenterne som noget spiseligt. Når man lever i mørke fjorde og navigerer med lyd, kan et bøjesystem 20 meter over havbunden måske godt forveksles med en godbid.
Fundene giver derfor stof til eftertanke, for i samme område er der tidligere fundet narhvaler, der er omkommet med liner fra lignende installationer. Forskerne må derfor genoverveje, hvor skånsom teknikken egentlig er.
Men …
Der er naturligvis forbehold. Undersøgelsen kommer fra ét fjordsystem, og man ved endnu ikke, om adfærden findes andre steder. Optagelserne dækker kun korte intervaller, så der kan være meget, man slet ikke har registreret. Og uden billeder fra dybet er det umuligt at sige, om hvalerne spiller, jager, undersøger eller bare har en dårlig dag med dårligt sigte. Men studiet viser, at det kan være svært at være til stede i naturen uden at blive opdaget.